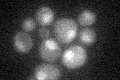
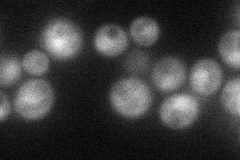
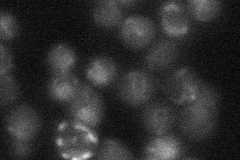
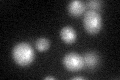

View description
Subunit of cohesin loading factor (Scc2p-Scc4p), a complex required for the loading of cohesin complexes onto chromosomes; involved in establishing sister chromatid cohesion during double-strand break repair via phosphorylated histone H2AX
Localization:
Intensity:
Fold change:
Significance:
-
C’ GFP library in SD
nucleus18.66 -
N' NOP1pr-GFP in SD
cytosol,nucleus44.4009 -
N' TEF2pr-mCherry in SD

cytosol,nucleus119.39 -
N' NATIVEpr-GFP in SD
punctate,nucleus20.829 -
N' TEF2pr-VC and Cyto-VN in SD

below threshold25.4249 -
C’ GFP library in SD+DTT
nucleus21.461.15No -
C’ GFP library in SD+H2O2

nucleus23.511.26No -
C’ GFP library in Starvation Media

nucleus17.620.94No -
C’ GFP library on the background of Pup2-DaMP

nucleus -
C’ GFP library on the background of CCT mutant

nucleus23.03751.23449No
